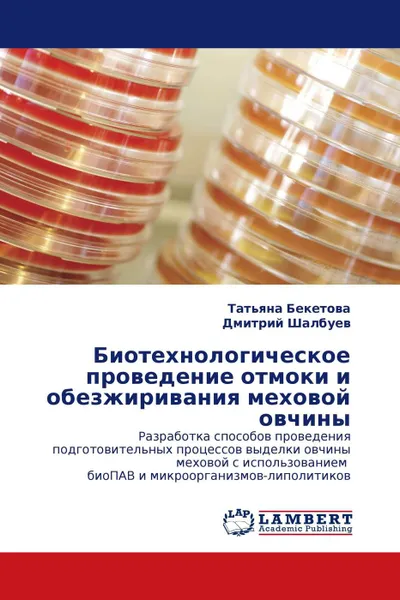
Обложка книги Биотехнологическое проведение отмоки и обезжиривания меховой овчины, Татьяна Бекетова, Дмитрий Шалбуев

Биотехнологическое проведение отмоки и обезжиривания меховой овчины
Автор: Татьяна Бекетова,
Дмитрий Шалбуев
2011
Переплёт: Мягкая обложка, 168 страниц
ISBN: 9783843302777
Тираж: 200
📗 Исследована возможность применения биологически разлагаемого белкового гидролизата, производимого из коллагенсодержащих отходов кожевенно-мехового производства, в качестве перспективного аналога синтетических ПАВ в отмоке меховой овчины, а также применение микроорганизмов с высокой липолитической активностью для обезжиривания меховой овчины, что позволит сократить расход синтетических ПАВ и исключить из состава рабочей жидкости высокотоксичный формалин. Изучены коллоидно-химические и токсикологические свойства синтетических ПАВ. Оптимизирована схема переработки коллагенсодержащих отходов в белковый гидролизат, разработаны параметры его применения в отмоке. Адаптированы к применению в обезжиривании микроорганизмы вида Bacillus pumilus, обладающие высокой деструктивной активностью в отношении жировых веществ овчины. Меховой полуфабрикат, выделанный по предлагаемой технологии, имеет высокие органолептические показатели (белизна волосяного покрова, мягкость и пластичность кожевой ткани). Технология позволяет снизить токсичность сточных вод после отмоки в 17,4 раза, после обезжиривания – в 32 раза по сравнению с типовой технологией.
Мнения